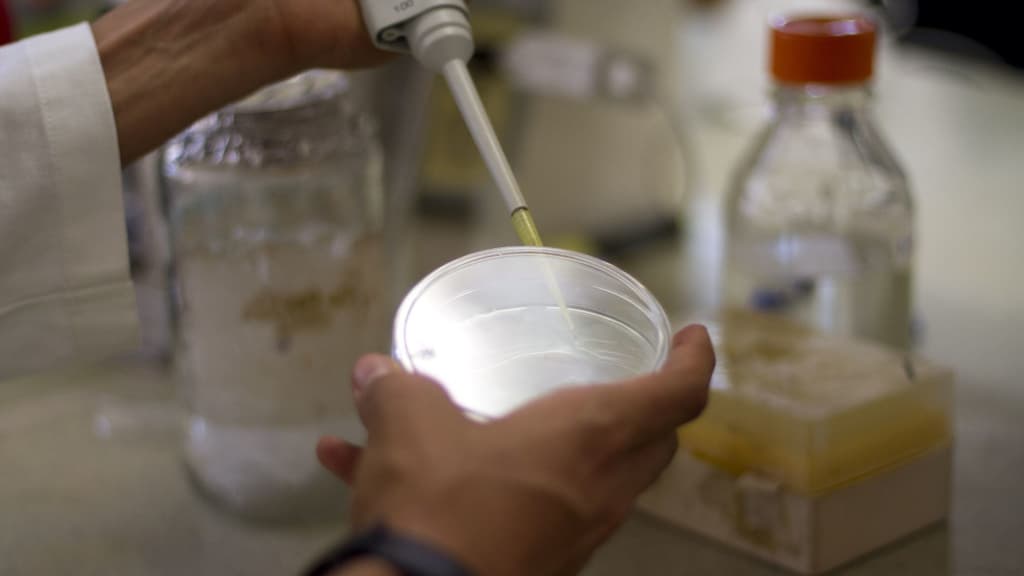
Hepatitis aguda grave

¿Quieres cuidar e integrar a tu familia a un michi? Habrá adopciones en el Gato Fest 2022. De acuerdo con la Agencia de Protección Animal de la Ciudad de México, hasta enero de 2020 se calculaban alrededor de 49…
¿Fue una buena decisión? ¿Qué medidas se deben tomar para que el ahuehuete en la Glorieta de la Palma permanezca sano? Esto dicen los especialistas. Luego del retiro de la palma de sobrevivió por 100 años en Paseo de…
¡Justo en la cartera! Debido a los festejos por el Día de las Madres, los costos de flores en el Mercado de Jamaica aumentaron hasta un 100%. El también conocido como Mercado de las Flores es un punto clave…
¿El helado será un buen regalo para la jefa? Te decimos el pronóstico del clima del 10 de mayo; toma nota. El Servicio Meteorológico Nacional (SMN) indicó que para este martes, la CDMX tendrá un clima bastante caluroso. Te…
Si ya no te sale el Ratón Vaquero, te truena la rodilla y aún no sabes dónde celebrar a tu jefita, acá te presentamos algunas de las celebraciones por el Día de las Madres 2022 en las alcaldías. De…
¡Preparen el brazo! Las autoridades municipales dieron a conocer los detalles de la vacunación de 12 años y más en Ecatepec. Se vacunará del miércoles 11 al viernes 13 de mayo. Te puede interesar: Hepatitis aguda grave: qué es…
¿Va parejo? Las autoridades indicaron que ya analizan la verificación para motocicletas. Luego de dar a conocer la situación de la calidad de aire en la Zona Metropolitana del Valle de México este 5 de mayo, explicaron que es…
¡Que la fuerza te acompañe! Habrá Expo Star Wars en la alcaldía Gustavo A. Madero (GAM). Toma nota, porque habrá proyecciones, conferencias, conciertos y hasta exhibiciones con sables de luz. Te puede interesar: Ármate el tour con estos recorridos…
¡Va de nuevo! Las autoridades informaron que se activa contingencia ambiental en Zona Metropolitana del Valle de México (ZMVM). La Comisión Ambiental de la Megalópolis (CAME) indicó que a las 16:00 horas de este 5 de mayo, se registraron…
¿Qué es? ¿Cuáles son los síntomas de la Hepatitis aguda grave? Acá te explicamos. Este 5 de mayo la Secretaría de Salud Federal, a través de la Unidad de Inteligencia Epidemiológica y Sanitaria (UIES) de la Dirección General de…